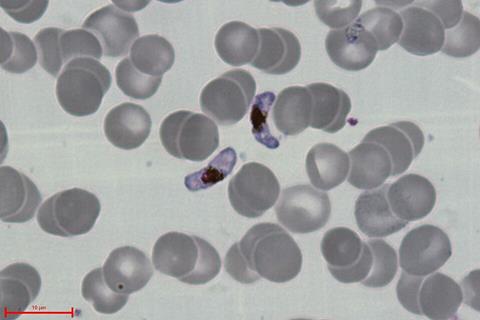

Today, more than 260 million people are infected each year with the parasite Plasmodium falciparum – the pathogen that causes malaria. In Germany, the annual number of cases is currently still in the three-digit range. However, experts expect these numbers to rise significantly due to ongoing climate change.
Although effective drugs based on artemisinin derivatives have been available since the mid-1990s, malaria infections claim around 600,000 lives every year. In addition to inadequate health care and medication, this is also due to the fact that the pathogen is becoming increasingly resistant to the active ingredients used.
READ MORE: Family of parasite proteins presents new potential malaria treatment target
READ MORE: Targeting malaria parasite’s protein control system could be key to innovative treatments
Against this background, there is an urgent need for new active ingredients that are capable of circumventing existing resistances. Together with partners from Swiss TPH and the companies BASF and OmicScouts, researchers at HIPS have now identified a new drug candidate, “Substance 31”, which could enable the development of a new malaria drug. HIPS is a site of the Helmholtz Centre for Infection Research in cooperation with Saarland University.
Substance library
The starting point for the discovery of Substance 31 was a large-scale screening of a substance library of the chemical company BASF with over 100,000 molecules. The original aim was to find substances that bind to the enzyme IspD and can thus specifically interfere with the metabolism of the malaria pathogen P. falciparum. At the same time, the efficiency of these candidates in killing the parasite was also tested.
“After identifying a number of promising molecules, we began to optimize them by modifying their chemical structure,” says Prof. Anna Hirsch, head of the HIPS department Drug Design and Optimization.
“Interestingly, with Substance 31, we now have a drug candidate that has good pharmaceutical properties and combats the malaria pathogen very efficiently, even though none of the activity against IspD originally observed remains.”
Selection pressure
But how does Substance 31 work if it does not bind to the original target protein? To get to the bottom of this question, the researchers treated the malaria pathogen with small amounts of Substance 31 over several days and then analyzed whether changes occurred in the parasite’s genome.
“By administering non-lethal amounts of our drug candidate, we exert selection pressure on P. falciparum. As a result, mutations manifest themselves in the parasite’s genome that allow it to survive even in the presence of the substance. Depending on which genes these mutations occur in, we can deduce how the tested substance might work or how the parasites successfully defend themselves against it,” says Dr Matthias Rottmann, project manager at Swiss TPH.
“By examining the proteome, i.e. all the proteins present in the pathogen, more closely, we were able to find out how Substance 31 works – namely by preventing the production of new proteins.”
Since the pathogen must constantly produce new proteins to maintain its cellular functions and stay alive, this is a promising target for a new active substance.
New mechanism of action
What makes Substance 31 particularly special is that it works differently from the artemisinins already used in malaria therapy. Only if a new active substance has a pharmaceutically unused mechanism of action it can break through existing resistances.
In addition, this novel mechanism of action has the potential to develop new therapeutic strategies for combating malaria infections. Another advantage of Substance 31 is that it has not shown any toxic effects on human cells in laboratory tests to date. In subsequent studies, the team now wants to investigate the molecule further and use it to develop a next generation of malaria drugs.
No comments yet